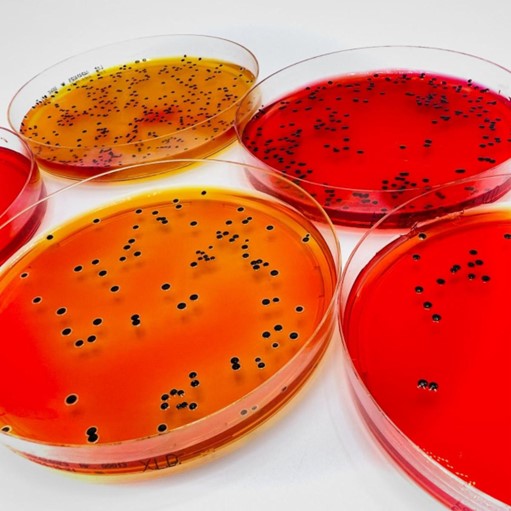

抗菌藥物耐藥性管理
即用型瓊脂稀釋平板


瓊脂稀釋法(AD)是磷霉素藥敏試驗的金標準方法。
瓊脂稀釋法也用于厭氧菌的幾種應用,如果與其他 AFST 方法相比,在使用 RPMI 和抗真菌劑時可以獲得更好的讀數。
即用型 AD 板有 12 孔或 24 孔格式,包含以不同濃度摻入瓊脂培養(yǎng)基中的抗生素。
AD 磷霉素 0.25 - 256
參考編號 77001 - 1 塊板/包
參考編號 77061 - 6 塊板/包
血液 AD 克林霉素 0.03 - 32
參考編號 77002 - 1 塊板/包
參考編號 77062 - 6 塊板/包
即用型瓊脂稀釋板可提供定制版本(使用諸如 Mueller Hinton、Mueller Hinton 苛養(yǎng)菌、FAA-HB、布魯氏菌血瓊脂、RPMI 等培養(yǎng)基以及 100 多種抗菌劑可供選擇),交貨期約 4 周。
食品安全的解決方案
MRS 瓊脂

用于分離和計數中溫乳酸菌的培養(yǎng)基,依據 ISO 15214生產。MRS 瓊脂是一種用于培養(yǎng)食品和飲料中乳桿菌屬的培養(yǎng)基。它還可能支持片球菌屬和明串珠菌屬以及其他次生細菌的生長。這種培養(yǎng)基符合 ISO 15214 和 APHA 的建議。
酪蛋白和肉提取物的酶解產物為生物體的生長提供氨基酸、氮、碳、維生素和礦物質。酵母提取物是維生素的來源,尤其是 B 族維生素。檸檬酸銨和乙酸鈉是對鏈球菌和霉菌有效的選擇性試劑。低 pH 值對除乳桿菌以外的大多數生物體也有抑制作用。硫酸鎂和硫酸錳是離子和硫酸鹽的來源,起生長刺激作用。磷酸氫二鉀是緩沖劑。葡萄糖是可發(fā)酵的碳水化合物。吐溫 80 是乳化劑。瓊脂是固化劑。
參考編號 412320
6 瓶×200 毫升
10 - 25°C 儲存溫度
保質期 2 年
XLD 瓊脂 EP, USP, JP
用于分離和鑒別革蘭氏陰性腸道桿菌
XLD 瓊脂 EP、USP、JP 配方是一種選擇性培養(yǎng)基,用于依據協調后的 EP、USP、JP 標準分離和鑒別革蘭氏陰性腸道桿菌,特別是志賀氏菌屬/普羅威登斯菌屬和沙門氏菌屬。
通過以下三個反應來區(qū)分沙門氏菌屬和志賀氏菌屬/普羅威登斯菌屬與非致病菌:木糖發(fā)酵、賴氨酸脫羧和硫化氫產生:
• 木糖、乳糖和蔗糖的降解產生酸,導致培養(yǎng)基從紅色變?yōu)辄S色。
• pH 值低時抑制硫化氫的產生,而在堿性條件下會導致形成帶有黑色中心的菌落。
• 在不存在乳糖和蔗糖發(fā)酵的情況下,賴氨酸脫羧導致恢復堿性條件,使培養(yǎng)基變回紅色。
沙門氏菌屬產生帶有黑色中心的紅色菌落。志賀氏菌屬和普羅威登斯菌屬產生紅色菌落。
參考編號 10413
20 塊/包;10 - 25°C 儲存溫度 保質期 6 個月